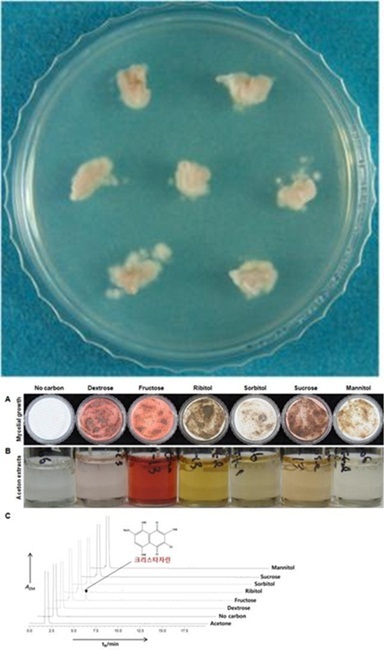
NSP통신-여러 가지 탄소원에서 키운 산호잔꽃지의 곰팡이(A), 아세톤 추출물(B) 및 HPLC를 통한 물질 검정(C) (순천대 한국지의류연구센터)

지역화제
순천대 허재선 교수팀, ‘천연 대사물질 보고’ 지의류 곰팡이 게놈 완전 해독
(전남=NSP통신 최창윤 기자) = 순천대학교 한국지의류연구센터(허재선 교수팀)는 환경부 소속 국립생물자원관과 함께 큰 일을 해냈다.
허재선 교수팀에 따르면 설악산에 자생하는 산호잔꽃지의(Cladonia metacorallifera)를 포함해 작고붉은열매지의(Cladonia macilenta), 방울주황단추지의(Caloplaca flavorubescens) 등 3종의 지의류로부터 순수분리한 지의류형성 곰팡이의 게놈을 완전 해독해 지의류 연구에 새로운 장을 열었다고 밝혔다.
환경오염의 지표로도 알려진 지의류는 곰팡이와 조류의 공생체로 극지방, 고산지대를 포함한 전 세계에 분포해 있다.
또 극한 환경에서도 잘 적응해 자라는 독특한 생물체로 예로부터 천연염료·식용·약용·화장품 재료 등으로 사용했고 특이한 대사물질을 만드는 것으로 알려졌다.
현재까지 1500여개 이상으로 알려진 지의류 물질은 생리활성이나 화학구조 규명 등에 대해서는 상당히 연구가 진척됐으나 자연 상태에서 생장이 매우 느리고 생물량이 적어 산업적 활용은 어려움을 겪고 있다.
이번 연구에서 순천대학교 한국지의류연구센터와 국립생물자원관 유전자원센터는 지의류에서 분리한 곰팡이를 단독 배양하여 공생체에서 나오는 물질을 만들어 낼 수 있는 인공배양 조건을 찾아냈다.
또한 게놈서열을 완전히 해독해 자연 생태계의 지의류를 남획하지 않고도 지의류 물질을 대량생산하기 위한 기반을 마련했다.
특히 곰팡이 게놈 해독에 특화된 생물정보 분석기술을 적용해 고품질의 게놈 지도로 재조립하고 물질 생합성에 관련된 유전자를 찾아냈다.
그 결과를 미국 미생물학회에서 발간하는 ‘게놈 어나운스먼트(Genome Announcements)’ 2013년 8월호, 9월호, 2014년 2월호 등에 게재했다.
이번 연구에 사용된 사슴지의속(Cladonia)은 전 세계 어느 곳에서나 흔히 볼 수 있는 지의류로 독특한 항암, 항산화 및 항생물질을 만든다. 이러한 화합물들은 폴리케타이드 생합성 경로를 통해서 만들어지는 것으로 알려져 있다.
산호잔꽃지의에서 분리한 지의류 곰팡이는 탄소원에 따라 다른 색깔의 색소를 만들어 냈는데 특히 과당(Fructose)이 든 배지에서 붉은색 색소와 함께 항암 및 항균 작용이 있는 지의류 물질인 크리스타자린을 생산하는 것으로 나타났다.
산호잔꽃지의 게놈서열에는 폴리케타이드 생합성 유전자가 약 30여개 존재하는 것으로 나타나 그동안 하나씩 오랜 시간과 노력을 들여 찾아내던 지의류의 물질 생합성 관련 유전자를 단시간에 쉽게 확보할 수 있게 됐다.
특히 개별 유전자들의 물질 생합성에 미치는 역할 규명이 한층 앞당길 것으로 기대하고 있다.
오경희 국립생물자원관 유전자원센터장은 “이번 연구는 지금까지 생리활성 규명이나 물질 탐색 수준에 머물던 지의류 대사물질의 생합성 메커니즘을 유전체 수준에서 규명하는 기반을 확립했다”고 밝혔다.
앞으로 “지의류 물질의 대량생산을 위한 시스템 확립과 조류(藻類)와의 공생에 관련된 유전자, 극한 환경에 적응하기 위한 유전자 등 다양한 유전자를 탐색함으로써 지의류가 생물다양성 증진에 미치는 역할을 유전체 차원에서 규명할 예정“이라고 강조했다.
nsp0223@nspna.com, 최창윤 기자(NSP통신)
<저작권자ⓒ 한국의 경제뉴스통신사 NSP통신. 무단전재-재배포 금지.>